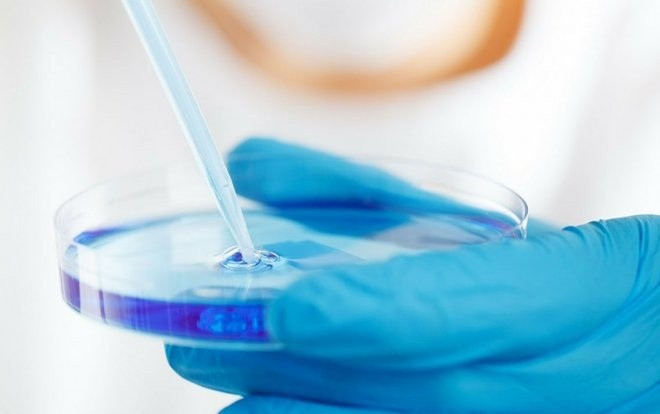
Hy hữu: Chồng bồi thường hơn 100 triệu cho vợ vì tự ý hủy lưu trữ phôi lạnh Ảnh 2

Tòa án nhân dân huyện Huyền Vũ, thành phố Nam Kinh, tỉnh Giang Tô ra phán quyết yêu cầu Fang Mu bồi thường số tiền trên cho vợ vì xâm phạm các quyền về sức khỏe và làm ảnh hưởng tới quá trình sinh nở của cô, theo China Daily.
Fang gặp Pei Pei năm 2004. Hai người kết hôn vào năm 2010 sau thời gian anh ta du học ở Mỹ nhưng cặp đôi bị chẩn đoán vô sinh sau 4 năm chung sống. Fang và Pei sau đó quyết định dùng phương pháp thụ tinh trong ống nghiệm tại một bệnh viện ở Mỹ.
Bệnh viện đã lấy 13 trứng từ cơ thể Pei và giữ lại nuôi 6 trứng. Các bác sĩ đã cấy ghép một quả trứng đã được thụ tinh vào cơ thể Pei và lưu trữ 5 trứng còn lại trong phòng đông lạnh để sử dụng khi cặp vợ chồng có yêu cầu.
Tuy nhiên, Pei bị sảy thai trước khi trở về Trung Quốc vào năm 2015. Đó cũng là giai đoạn quan hệ giữa hai vợ chồng cô xấu đi.
Tháng 7/2016, Fang nộp đơn ly hôn nhưng bị từ chối giải quyết vì tòa án tin hai người vẫn có tình cảm với nhau. Tuy nhiên, Pei không hề hay biết 5 phôi cô lưu trữ ở Mỹ đã bị hủy, mãi tới khi Fang tiếp tục gửi đơn ly hôn lên tòa án vào tháng 6/2017.
Theo phía bệnh viện ở Mỹ, họ hủy mẫu phôi lưu trữ của vợ chồng Fang vì anh ta đã dừng thanh toán chi phí bảo quản từ tháng 3/2016.

Ành minh họa: Pixabay
Trước tòa án, Fang cho rằng, giống như phụ nữ, đàn ông có quyền lựa chọn không có con. Anh ta cũng nói không muốn liên lạc với Pei sau khi ly hôn và anh ta có quyền ngừng lưu trữ phôi thai.
Tuy nhiên, theo thẩm phán Chen Wenjun, người phụ nữ chịu nhiều rủi ro về sức khoẻ hơn nam giới trong quá trình thụ tinh trong ống nghiệm. “Rủi ro và đau đớn tồn tại trước và trong quá trình thu hoạch trứng từ cơ thể của phụ nữ. Anh ta (Fang) đã xâm phạm quyền được biết tình trạng lưu trữ phôi của vợ và dừng trả chi phí dịch vụ này khi không có sự đồng ý của cô ấy”, thẩm phán Chen lập luận.
Ông Chen nói, các ông chồng cần tôn trọng sự hy sinh của vợ trong quá trình thụ tinh trong ống nghiệm và không nên tự ý hủy lưu trữ phôi mà không có sự đồng ý của người phụ nữ.
Lan Tianbin, luật sư của Công ty luật Dongheng Giang Tô, nhận định bản án của tòa dành cho Fang là công bằng. “Luật pháp cần bảo vệ các quyền của phụ nữ khi có xung đột về quyền sinh sản giữa vợ chồng. Phụ nữ là bên chịu nhiều rủi ro sức khỏe và áp lực tâm lý trong quá trình sinh sản”, luật sư Lan nói.
Đây là lần đầu tiên Trung Quốc ghi nhận vụ kiện liên quan tới tranh cãi lưu trữ phôi giữa cặp vợ chồng.